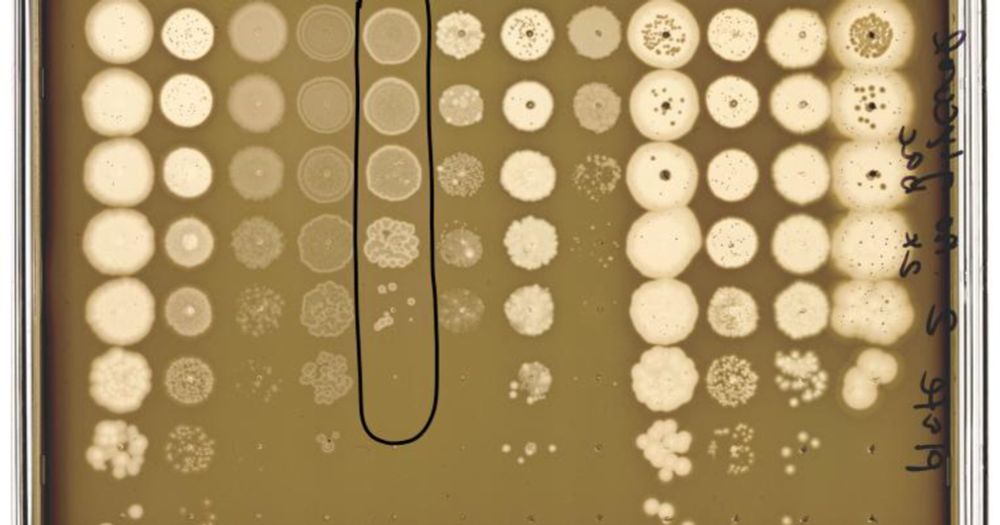

Paul Turner Lab
@paulturnerlab.bsky.social
2.2K followers
800 following
9 posts
Experimental evolution of viruses for basic science and evolutionary medicine at Yale Ecology & Evolutionary Biology.
Tweeting papers & news from our group. Acct managed by lab members.
Posts
Media
Videos
Starter Packs
Reposted by Paul Turner Lab
Reposted by Paul Turner Lab
Reposted by Paul Turner Lab
Jyot Antani
@antanij.bsky.social
· May 8
INCATE
@incate.bsky.social
· May 6

Personalized inhaled bacteriophage therapy for treatment of multidrug-resistant Pseudomonas aeruginosa in cystic fibrosis - Nature Medicine
A novel personalized phage therapy strategy that selects phages for a predicted evolutionary trade-off may represent a viable alternative approach for the treatment of antimicrobial-resistant bacteria...
www.nature.com
Reposted by Paul Turner Lab
Nora Pyenson
@norapyenson.bsky.social
· Dec 12

Diverse phage communities are maintained stably on a clonal bacterial host
Bacteriophages are the most abundant and phylogenetically diverse biological entities on Earth, yet the ecological mechanisms that sustain this extraordinary diversity remain unclear. In this study, w...
www.science.org
Reposted by Paul Turner Lab
Reposted by Paul Turner Lab
Meaghan Castledine
@mcastd.bsky.social
· Nov 15

Critically evaluating the relative importance of phage in shaping microbial community composition
The ubiquity of bacteriophages (phages) and the major evolutionary and ecological
impacts they can have on their microbial hosts has resulted in phages often cited
as key drivers shaping microbial com...
www.cell.com